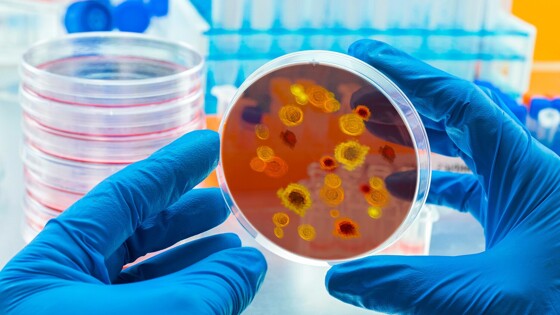

Россиянам не нужно начинать мыть все фрукты с мылом, так как выживаемость вирусов на поверхностях не так высока, в том числе это касается вируса Марбург. Объяснить жителям это нужно в специальной памятке на тему заболевания, отметил академик РАН и бывший главный санитарный врач России Геннадий Онищенко в беседе с Общественной Службой Новостей.
До этого в СМИ появились сообщения, что якобы Марбург можно подхватить через немытые бананы и другие фрукты. Однако Онищенко с этим не согласился.
«Мыть бананы с мылом не надо — это я вам сразу говорю. Потому что выживаемость вируса на поверхностях – я бы не сказал, что она имеет такое [большое значение]. Это сибирская язва может 100 лет пробыть в земле, а потом, как только попадет в организм, сразу проснуться. А это вирусы», — подчеркнул эпидемиолог.
Он назвал преувеличенную информацию об угрозе вируса следствием отсутствия достоверных данных, разъяснений от представителей государственных структур. Решить эту проблему, по мнению Онищенко, могли бы специальные памятки, объединяющие информацию о том, что нужно делать для снижения угрозы заражения вирусом Марбург. Лучше выпустить такие информационные материалы, чем тратить мыло на мытье бананов, заключил эксперт.
До этого доктор медицинских наук, бывший главный инфекционист Москвы, профессор Николай Малышев заявил, что россиянам нужно заботиться о здоровье и защищаться от массы угроз и вирусов, а не только Марбурга. По его словам, фрукты и овощи мыть надо непременно, так как в противном случае можно подхватить множество инфекций и паразитов. Также он посоветовал оставлять ягоды в воде на некоторое время, а бутылки и консервные банки перед открытием хорошенько протирать.